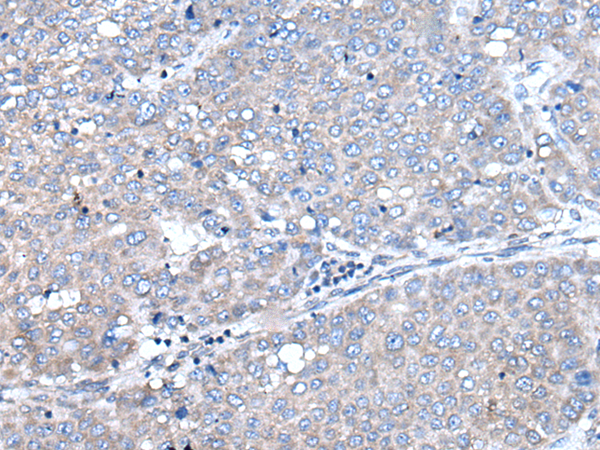

技術規格
|
Background: |
This gene encodes the extracellular cholesterol esterifying enzyme, lecithin-cholesterol acyltransferase. The esterification of cholesterol is required for cholesterol transport. Mutations in this gene have been found to cause fish-eye disease as well as LCAT deficiency. |
|
Applications: |
ELISA, IHC |
|
Name of antibody: |
LCAT |
|
Immunogen: |
Fusion protein of human LCAT |
|
Full name: |
lecithin-cholesterol acyltransferase |
|
SwissProt: |
P04180 |
|
ELISA Recommended dilution: |
2000-5000 |
|
IHC positive control: |
Human liver cancer |
|
IHC Recommend dilution: |
25-100 |
購物車
購物車 幫助
幫助
 021-54845833/15800441009
021-54845833/15800441009
